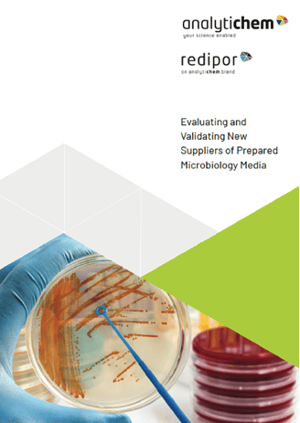
Evaluating and Validating New Suppliers of Prepared Microbiology Media Guide

Evaluating and Validating Potential New Suppliers of Prepared Microbiology Media
Written By: Steven Brimble |
Selecting a new supplier of prepared microbiology media is a significant decision in pharmaceutical and GMP-regulated environments. To manage risk effectively, supplier approval must follow a structured process that clearly separates evaluation from validation, while ensuring both are robust and well documented.
This article outlines a GMP-aligned approach to both stages, covering:
- Key regulatory and GMP considerations during supplier selection
- How to evaluate potential new suppliers of prepared microbiology media before embarking upon validation
- The role of product configuration, adaptability, and audits in supplier evaluation
- Why validation is essential once a supplier has been selected
- How validation builds on evaluation to confirm supplier suitability through documented evidence
- The importance of comparative testing, defined acceptance criteria, and validation protocols in supplier approval
- How testing, batch consistency, stability, and change control support long-term compliance
Evaluation and Validation: Essential to Ensure Confidence in Prepared Media Suppliers
Forming a relationship with a new supplier of prepared microbiology media for environmental monitoring requires careful planning and control. Any supplier must be able to consistently deliver products that meet regulatory requirements and perform reliably.
Two distinct but complementary processes underpin this decision-making:
- Evaluation assesses capability, compliance, and operational fit to establish whether a supplier is suitable to proceed to the costly and time-consuming validation stage.
- Validation provides the documented evidence needed to confirm that the supplier's prepared microbiology media products perform consistently and reliably under defined conditions.
Evaluation and validation are equally important processes, and maintaining the distinction between them is essential for effective GMP-aligned supplier approval.
Evaluating Suppliers of Prepared Microbiology Media
Establishing Suitability
A fundamental part of supplier evaluation is confirming that their prepared microbiology media products meet relevant regulatory and quality standards.
In pharmaceutical and GMP-regulated environments, suppliers must demonstrate compliance with applicable pharmacopeial requirements. This includes confirming that media formulation and performance—such as productivity ratios—align with defined acceptance criteria.
As part of the evaluation process, customers should always request and review a Certificate of Analysis (CoA). This should clearly document:
- Test organisms used and their culture collection references
- Test methodologies and acceptance criteria
- Evidence of compliance with relevant standards
Reviewing this information provides early assurance that the supplier understands regulatory expectations and applies appropriate quality controls.
Product Configuration and Supplier Adaptability
Beyond regulatory compliance, practical suitability is equally important. Media configuration must align with operational requirements.
For example, if processes depend on bottled media with snap caps, a supplier unable to provide this format is likely to introduce unnecessary disruption to your workflow.
Evaluation should also consider a supplier’s ability to adapt as your requirements evolve. Flexibility in packaging options, formats, volumes, and scalability is essential to support future growth, and changing contamination control strategies.
On-Site Audits and Facility Assessment
Document review alone is rarely sufficient to determine whether a supplier is ready to proceed to the validation stage. Where practical, on-site audits provide valuable insight into how a supplier operates in practice.
Key areas that can be more effectively assessed during an on-site audit include:
- Raw material sourcing and control
- Contamination control measures
- Storage conditions and operational practices
- Cleanroom classification and environmental monitoring practices
- Quality control testing, including evidence of product homogeneity and stability
Reviewing the potential supplier's batch testing approaches—such as sampling from the start, middle, and end of production runs—also helps determine consistency and robustness across manufacturing processes.
Communication and Risk Management
A supplier’s ability to respond effectively when issues arise is a critical evaluation criterion. Complaint handling processes should be reviewed to understand how deviations, failures, or urgent supply issues are identified, investigated, and resolved.
As part of a broader risk mitigation strategy, some organizations also maintain secondary suppliers. While these may not support routine volumes, they often benefit from greater agility compared with their larger counterparts. This can be valuable in maintaining continuity should a primary supplier experience a supply chain disruption.
Only once a supplier has successfully passed the evaluation stage should validation be considered.
Validating Suppliers of Prepared Microbiology Media
Performance and Consistency
Validation focuses on performance, reproducibility, and control, ensuring confidence before a supplier is approved for ongoing use.
This stage provides the documented evidence required to confirm that prepared microbiology media products perform as intended in routine use. It demonstrates consistency, reliability, and compliance under defined conditions, building directly on the outcome of successful evaluation.
Comparative Testing and Microbiological Performance
Validation commonly involves comparative testing of media from the potential new supplier against existing, approved products. This helps confirm equivalent performance across multiple batches.
Microbiological performance testing assesses the ability of the media to support the growth of specified organisms listed in pharmacopeia. Recovery rates must meet defined acceptance criteria to demonstrate suitability for use.
In some cases, testing may extend beyond minimum regulatory requirements by including additional organisms, providing broader performance assurance and greater confidence in routine application.
Managing Product Variations
Even when media formulations remain unchanged, variations such as packaging modifications or manufacturing adjustments can influence performance. Validation should account for these variables to ensure continued compliance.
Validation protocols often include quantitative controls to confirm consistent recovery rates. Test methods must align with defined performance criteria, and may incorporate challenge testing to assess inhibition or expected absence of growth, where appropriate.
Batch Testing and Validation Protocols
Assessing multiple batches is essential to demonstrate lot-to-lot consistency and identify any variability. While testing three batches is commonly used as a minimum, the exact number should be determined based on product characteristics and internal risk assessments.
Clear acceptance criteria should be defined before testing begins and documented within a validation protocol. A well-structured protocol provides a consistent framework for evaluating results and supports audit readiness.
Long-Term Stability and Shelf Life
Validation should also consider long-term product stability to ensure that media performance is maintained throughout shelf life. Shelf-life data provided by the supplier forms an important part of validation evidence.
Routine stability testing helps confirm that products remain fit for purpose under defined storage and handling conditions.
Change Control and Documentation
Transitioning to a new supplier requires robust change control and thorough documentation. Validation records should typically include:
- Approved validation protocols
- Test results and supporting data
- Risk assessments
- Performance Qualification (PQ) reports confirming acceptance criteria have been met
Ongoing performance monitoring following implementation supports continued compliance and long-term confidence.
Confidence Through Structured Evaluation and Validation
Evaluation and validation serve different but equally important purposes; treating them as distinct activities is essential for effective GMP-aligned supplier approval. Together, they represent a structured, risk-based approach that supports informed decision-making, safeguards product quality, and maintains operational continuity.
Following these structured approaches helps ensure that any new supplier can deliver the products you need in a consistent and timely manner, and in line with regulatory requirements.
For more information about Redipor prepared microbiology media, or to request a quote, contact our team.
Steven Brimble is Director of Quality and Technology at AnalytiChem UK.
